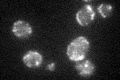
YOR330C

View description
Catalytic subunit of the mitochondrial DNA polymerase; conserved C-terminal segment is required for the maintenance of mitochondrial genome; related to human POLG, which has been associated with mitochondrial diseases
Localization:
Intensity:
Fold change:
Significance:
-
C’ GFP library in SD

mitochondria26.72 -
N' NOP1pr-GFP in SD

mitochondria32.316 -
N' TEF2pr-mCherry in SD

missing0 -
N' NATIVEpr-GFP in SD

missing0 -
N' TEF2pr-VC and Cyto-VN in SD

#N/A0 -
C’ GFP library in SD+DTT
mitochondria22.90.85No -
C’ GFP library in SD+H2O2

mitochondria30.041.12No -
C’ GFP library in Starvation Media

mitochondria28.51.06No -
C’ GFP library on the background of Pup2-DaMP

mitochondria -
C’ GFP library on the background of CCT mutant

mitochondria27.66421.03461No
